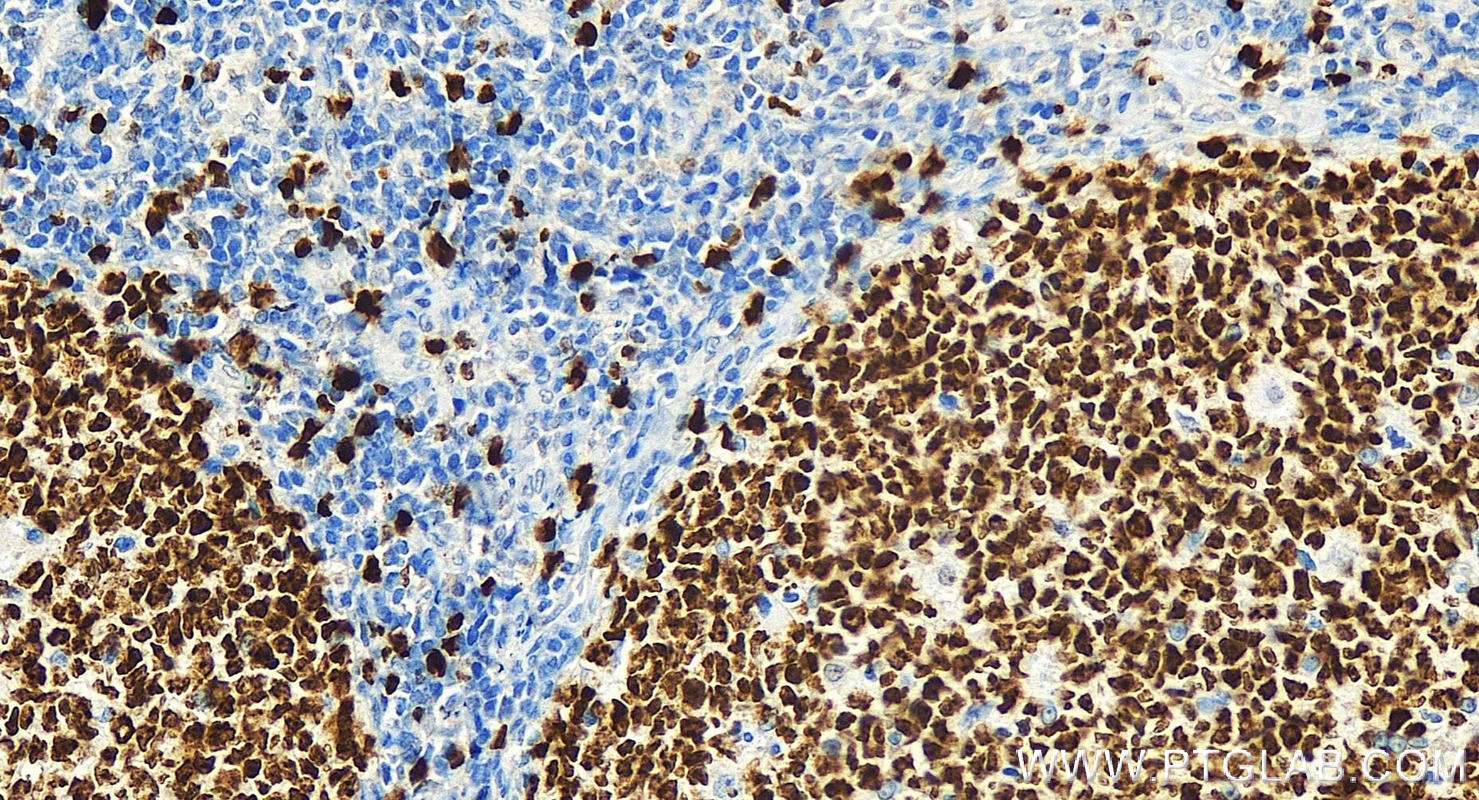

验证数据展示
经过测试的应用
| Positive IHC detected in | human tonsillitis tissue, human colon cancer tissue, human gliomas tissue, human lung cancer tissue, human skin cancer tissue, human lymphoma tissue, human breast cancer tissue, Insulinoma tissue, K-562 cells Note: suggested antigen retrieval with TE buffer pH 9.0; (*) Alternatively, antigen retrieval may be performed with citrate buffer pH 6.0 |
| Positive IF-P detected in | human lung cancer tissue |
| Positive IF/ICC detected in | HeLa cells, HEK-293 cells |
| Positive FC (Intra) detected in | Jurkat cells |
推荐稀释比
| 应用 | 推荐稀释比 |
|---|---|
| Immunohistochemistry (IHC) | IHC : 1:4000-1:16000 |
| Immunofluorescence (IF)-P | IF-P : 1:50-1:500 |
| Immunofluorescence (IF)/ICC | IF/ICC : 1:50-1:500 |
| Flow Cytometry (FC) (INTRA) | FC (INTRA) : 0.40 ug per 10^6 cells in a 100 µl suspension |
| It is recommended that this reagent should be titrated in each testing system to obtain optimal results. | |
| Sample-dependent, Check data in validation data gallery. | |
产品信息
27309-1-AP targets Ki-67 in IHC, IF/ICC, IF-P, FC (Intra), ELISA applications and shows reactivity with human samples.
| 经测试应用 | IHC, IF/ICC, IF-P, FC (Intra), ELISA Application Description |
| 文献引用应用 | IHC, IF, FC (Intra) |
| 经测试反应性 | human |
| 文献引用反应性 | human, pig, canine, zebrafish, hamster, goat |
| 免疫原 |
CatNo: Ag26266 Product name: Recombinant human KI67 protein Source: e coli.-derived, PGEX-4T Tag: GST Domain: 1201-1300 aa of NM_002417 Sequence: AGTLPGSKRQLQTPKEKAQALEDLAGFKELFQTPGHTEELVAAGKTTKIPCDSPQSDPVDTPTSTKQRPKRSIRKADVEGELLACRNLMPSAGKAMHTPK 种属同源性预测 |
| 宿主/亚型 | Rabbit / IgG |
| 抗体类别 | Polyclonal |
| 产品类型 | Antibody |
| 全称 | antigen identified by monoclonal antibody Ki-67 |
| 别名 | KI67, MKI67, Antigen identified by monoclonal antibody Ki-67, Antigen KI-67, Ki 67 |
| 计算分子量 | 359 kDa |
| GenBank蛋白编号 | NM_002417 |
| 基因名称 | KI67 |
| Gene ID (NCBI) | 4288 |
| RRID | AB_2756525 |
| 偶联类型 | Unconjugated |
| 形式 | Liquid |
| 纯化方式 | Antigen affinity purification |
| UNIPROT ID | P46013 |
| 储存缓冲液 | PBS with 0.02% sodium azide and 50% glycerol, pH 7.3. |
| 储存条件 | Store at -20°C. Stable for one year after shipment. Aliquoting is unnecessary for -20oC storage. |
背景介绍
The Ki-67 protein (also known as MKI67) is a cellular marker for proliferation. Ki67 is present during all active phases of the cell cycle (G1, S, G2 and M), but is absent in resting cells (G0). Cellular content of Ki-67 protein markedly increases during cell progression through S phase of the cell cycle. Therefore, the nuclear expression of Ki67 can be evaluated to assess tumor proliferation by immunohistochemistry. It has been demonstrated to be of prognostic value in breast cancer. In head and neck cancer, several studies have reported an association between high proliferative activity and poorer prognosis.
实验方案
| Product Specific Protocols | |
|---|---|
| FC protocol for Ki-67 antibody 27309-1-AP | Download protocol |
| IF protocol for Ki-67 antibody 27309-1-AP | Download protocol |
| IHC protocol for Ki-67 antibody 27309-1-AP | Download protocol |
| Standard Protocols | |
|---|---|
| Click here to view our Standard Protocols |
发表文章
| Species | Application | Title |
|---|---|---|
Signal Transduct Target Ther FBXW7β loss-of-function enhances FASN-mediated lipogenesis and promotes colorectal cancer growth | ||
Mol Cancer lncRNA ZNRD1-AS1 promotes malignant lung cell proliferation, migration, and angiogenesis via the miR-942/TNS1 axis and is positively regulated by the m6A reader YTHDC2 | ||
Mol Cancer Cell surface CD55 traffics to the nucleus leading to cisplatin resistance and stemness by inducing PRC2 and H3K27 trimethylation on chromatin in ovarian cancer | ||
Cancer Discov Stress Granules determine the Development of Obesity-associated Pancreatic Cancer. | ||
Adv Mater Supramolecular Hydrogel with Ultra-Rapid Cell-Mediated Network Adaptation for Enhancing Cellular Metabolic Energetics and Tissue Regeneration | ||
Protein Cell NDFIP1 limits cellular TAZ accumulation via exosomal sorting to inhibit NSCLC proliferation |